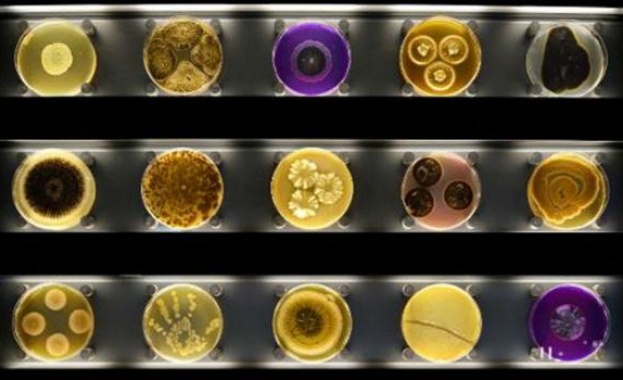

-
 22 Ноем 2024 |
22 Ноем 2024 |
 USD / BGN 1.8581
USD / BGN 1.8581 GBP / BGN 2.3487
GBP / BGN 2.3487 CHF / BGN 2.1044
CHF / BGN 2.1044- Радиация: София 0.11 (µSv/h)
- Времето:
 София 0°C
София 0°C 
Музей на микробите отваря врати в Амстердам
11 Януари 2015 | 16:37
/КРОСС/ В Амстердам отваря врати музей на микробите „Micropia museum". Експонатите в него ще са микоорганизми, които не се срещат в ежедневието. Те се съхраняват в специални тръби, което позволява на гостите да ги проучат в най-малки детайли. Всеки посетител ще може да сканира тялото си и да разбере колкото точно микроорганизми го обитават. Отделна експозиция пък е посветена на учените, които работят с бактерии и вируси. През стъклото гостите ще могат да наблюдават работата на хората в престилки. Музеят предлага и прожекция на филми за развитието на микроорганизмите.
За създаването на уникалния музей са похарчени 10 милиона евро. Билетът за възрастни ще струва 14 евро, а за деца - 12 евро. Учениците ще могат да видят всички микроорганизми с 50% отстъпка.